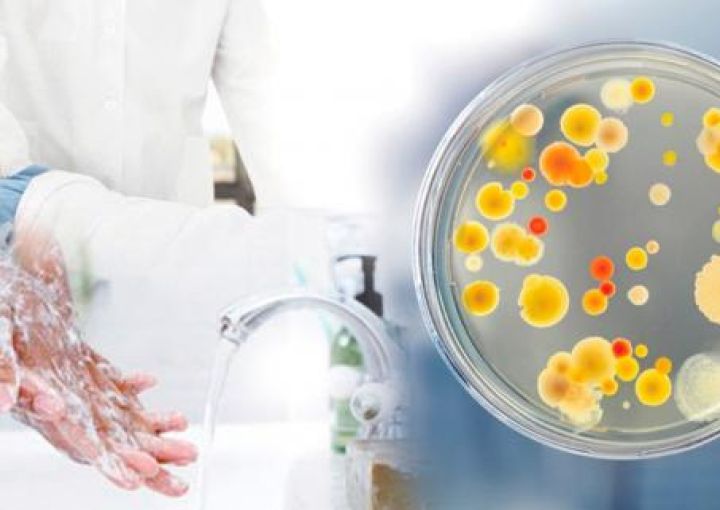

Як вберегти себе і своїх дітей від інфекції?
Кишкові інфекції – це велика група патологій, причиною розвитку яких є проникнення в шлунково-кишковий тракт патогенних бактерій або вірусів, джерелом зараження яких можуть бути брудні руки, вода, предмети побуту та продукти харчування.
Які небезпеки інфекційної природи підстерігають нас і наших дітей спекотної пори року?
Саме літньої пори діти не відвідують школу, а значить, частіше надані самі собі, адже у батьків канікул, на жаль, немає. Ось і виходить, що протягом дня дитина їсть що хоче, не стежить за гігієною, а може ще і збігати до найближчої водойми, покупатися з друзями. Все це…
Читати далі











